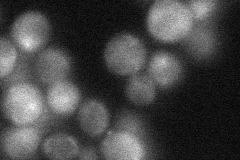
YKL079W
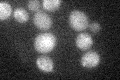
YKL079W

View description
Protein that interacts with Myo2p, proposed to be involved in exocytosis; N-terminal domain is related to the motor domain of kinesins
Localization:
Intensity:
Fold change:
Significance:
-
C’ GFP library in SD

below threshold18.39 -
N' NOP1pr-GFP in SD

cytosol,punctate63.1496 -
N' TEF2pr-mCherry in SD

bud73.8076 -
N' NATIVEpr-GFP in SD
cytosol32.6121 -
N' TEF2pr-VC and Cyto-VN in SD

cytosol50.3495 -
C’ GFP library in SD+DTT

cytosol18.981.03No -
C’ GFP library in SD+H2O2
cytosol19.781.07No -
C’ GFP library in Starvation Media

cytosol21.651.17No -
C’ GFP library on the background of Pup2-DaMP

below threshold -
C’ GFP library on the background of CCT mutant

below threshold17.23010.936604No
